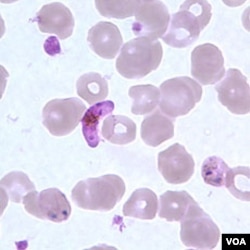
Parasit baru malaria yang mematikan, plasmodium vivax (tengah warna ungu), di antara sel-sel darah manusia (foto: dok).

Persis ketika para pakar kesehatan mengira mereka telah memenangkan pertarungan melawan malaria - penyakit yang membunuh hampir 800.000 orang di seluruh dunia setiap tahun – salah satu jenis parasit malaria yang tadinya dianggap tidak berbahaya, kini justru menjadi ancaman besar bagi kesehatan masyarakat.
Jenis parasit itu jauh lebih rumit dan mematikan daripada parasit yang sekarang dijadikan target vaksin.
Malaria yang disebabkan oleh plasmodium vivax sejak lama dianggap jauh lebih jinak daripada malaria yang disebabkan oleh plasmodium falciparum, yang prevalensinya tinggi di Afrika. Tetapi data global baru tersebut menunjukkan bahwa hal itu tidak benar, kata Peter Gething dari Universitas Oxford, yang berbicara kepada VOA melalui Skype.
"Plasmodium vivax merupakan masalah kesehatan masyarakat yang sangat besar secara global. Parasit ini membunuh lebih banyak manusia daripada yang tadinya diperkirakan, dan sebenarnya lebih banyak manusia yang berisiko tertular vivax secara global dibanding plasmodium falciparum," ujar Gething.
Peter Gething adalah peneliti utama Proyek Atlas Malaria, sebuah upaya baru untuk memantau perubahan prevalensi malaria di seluruh dunia.
Gething mengatakan sekitar 2,8 milyar orang berisiko terkena jenis baru malaria ini. Ia menambahkan bahwa peralatan untuk melawan berbagai penyakit itu mulai dari tidak efektif sampai tidak ada.
"Fakta penting adalah vivax bukan masalah besar bagi kesehatan masyarakat di Afrika, di mana falciparum dominan. Vivax merupakan masalah besar di negara-negara yang padat penduduknya - jadi ini adalah masalah yang sangat signifikan, misalnya, di India, Indonesia, dan di sebagian besar Asia tengah dan Asia Tenggara," tambahnya.
Para pakar di lapangan juga mencatat bahwa langkah-langkah pengendalian seperti kelambu yang telah diberi pestisida tidak manjur terhadap parasit vivax, karena nyamuk pembawanya lebih mungkin menggigit korban mereka di luar rumah daripada di dalam.
Gething mengatakan, "Plasmodium vivax bisa berhibernasi di dalam hati atau liver manusia dan bisa berada disana berbulan-bulan atau bahkan bertahun-tahun. Ketika parasit pada tahap itu berada di dalam liver atau hati, parasit ini tidak bisa diobati dengan obat-obatan melalui aliran darah yang kita gunakan untuk melawan falciparum. Jadi, kita bisa mengobati orang itu dan mereka bisa pulih, tetapi tidak akan menyembuhkan penyakit itu sendiri."
Obat yang paling dikenal untuk mengobati malaria akibat vivax adalah primakuin, tetapi diperlukan waktu 14 hari untuk pengobatan yang sulit untuk dipatuhi di banyak daerah rawan malaria di dunia. Obat itu juga menimbulkan efek samping yang serius pada pasien yang mewarisi gangguan darah, yang cukup umum di daerah-daerah di mana vivax endemik. Riset sudah dimulai atas beberapa obat baru yang menjanjikan untuk melawan parasit malaria vivax.